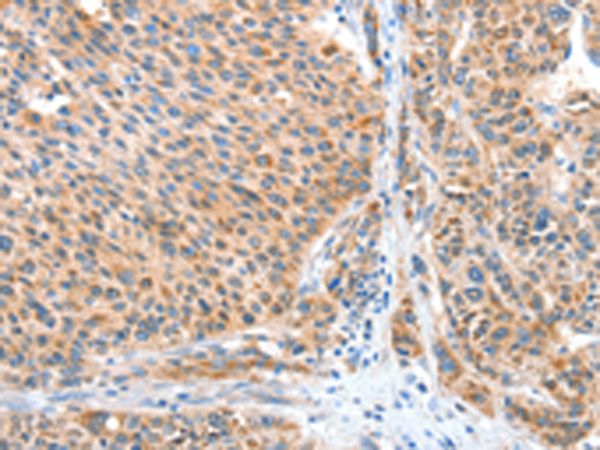

中文名稱:兔抗CASP7多克隆抗體
英文名稱: Anti-CASP7 rabbit polyclonal antibody
別 名: MCH3; CMH-1; LICE2; CASP-7; ICE-LAP3
相關類別: 一抗
抗 原: CASP7
儲 存: 冷凍(-20℃)
宿 主: Rabbit
反應種屬: Human, Mouse
標 記 物: Unconjugate
克隆類型: rabbit polyclonal
技術規(guī)格
|
Background: |
This gene encodes a member of the cysteine-aspartic acid protease (caspase) family. Sequential activation of caspases plays a central role in the execution-phase of cell apoptosis. Caspases exist as inactive proenzymes which undergo proteolytic processing at conserved aspartic residues to produce two subunits, large and small, that dimerize to form the active enzyme. The precursor of the encoded protein is cleaved by caspase 3 and 10, is activated upon cell death stimuli and induces apoptosis. Alternatively spliced transcript variants encoding multiple isoforms have been observed for this gene. |
|
Applications: |
ELISA, WB, IHC |
|
Name of antibody: |
CASP7 |
|
Immunogen: |
Fusion protein of human CASP7 |
|
Full name: |
caspase 7, apoptosis-related cysteine peptidase |
|
Synonyms: |
MCH3; CMH-1; LICE2; CASP-7; ICE-LAP3 |
|
SwissProt: |
P55210 |
|
ELISA Recommended dilution: |
1000-2000 |
|
IHC positive control: |
Human liver cancer and human lung cancer |
|
IHC Recommend dilution: |
25-100 |
|
WB Predicted band size: |
34 kDa |
|
WB Positive control: |
Mouse brain tissue |
|
WB Recommended dilution: |
200-1000 |

購物車
幫助
021-54845833/15800441009
